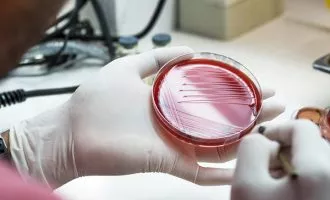

باکتری
آخرین مطالب (صفحه 3)
-
علمی باکتریها در فضا کشندهتر و در برابر آنتی بیوتیکها مقاومتر هستند
یافتههای جدید نشان دادهاند قرار گرفتن در شرایط خلا و حضور باکتریها در فضا باعث میشود تغییراتی در رفتار و کارایی سلولها ایجاد شود که ...
![]() ۲۰ مرداد ۱۳۹۹
۲۰ مرداد ۱۳۹۹
-
تکنولوژی سامسونگ ITFIT UV Sterilizer معرفی شد؛ ضدعفونی و شارژ گوشی به طور همزمان
سامسونگ از دستگاه ضدعفونی کننده گوشی با استفاده از نور فرابنفش رونمایی کرد. این وسیله ۵۱ دلاری که ITFIT UV Sterilizer نام دارد، تا ۹۹ ...
![]() ۱۳ تیر ۱۳۹۹
۱۳ تیر ۱۳۹۹
-
علمی دانشمندان با یک هورمون خاص باکتری را مجبور به تولید آنتی بیوتیک کردند
محققان در دانشگاه «ایلینوی در اربانا شمپین» توانستند با ترساندن باکتری به وسیله یک هورمون خاص، آن را مجبور به تولید آنتی بیوتیک کنند. به ...
![]() ۸ تیر ۱۳۹۹
۸ تیر ۱۳۹۹
-
تکنولوژی شرکت Zagg از دو دستگاه ضدعفونی کننده گوشی با نور فرابنفش رونمایی کرد
شرکت آمریکایی Zagg که در زمینه تولید لوازم جانبی موبایل فعالیت میکند، از دو دستگاه ضدعفونی کننده گوشی بوسیله نور فرابنفش رونمایی نمود. کیس اول ...
![]() ۶ تیر ۱۳۹۹
۶ تیر ۱۳۹۹
-
علمی محققان از احتمال وجود حیات در سیارات با اتمسفر کاملا هیدروژنی خبر میدهند
مطالعات جدید نشان میدهند که باکتری E. coli و مخمر میتوانند در اتمسفری که به طور ۱۰۰ درصد از هیدروژن تشکیل شده، زنده بمانند. یافتههای ...
![]() ۱۷ اردیبهشت ۱۳۹۹
۱۷ اردیبهشت ۱۳۹۹
-
علمی نابودی سریع باکتری از سطوح فلزی با کمک لیزر؛ دستاورد محقق ایرانی
پاتوژنهای باکتریایی میتوانند تا روزها روی سطوح مختلف زندگی کنند. به تازگی مهندسان دانشگاه پردو توانستهاند با کمک لیزر و ایجاد بافت به روشی دست ...
![]() ۲۳ فروردین ۱۳۹۹
۲۳ فروردین ۱۳۹۹
-
علمی از سیاهزخم تا بوتولیسم؛ مروری بر مرگبارترین سلاحهای بیولوژیک تاریخ
به استفاده آگاهانه از هرگونه عامل بیماریزا همانند ویروس، باکتری و یا مواد سمی برای صدمه زدن به مردم، حیوانات و طبیعت، جنگ زیستی یا ...
![]() ۷ فروردین ۱۳۹۹
۷ فروردین ۱۳۹۹
-
تکنولوژی ساخت بتن زنده به کمک باکتری با قابلیت جذب دی اکسید کربن
محققان دانشگاه کلرادو بولدر آمریکا (University of Colorado Boulder) با استفاده از باکتری موفق به ساخت نوعی بتن زنده شدند که دی اکسید کربن را ...
![]() ۲۷ دی ۱۳۹۸
۲۷ دی ۱۳۹۸
-
علمی توسعه گونهای از باکتری E. coli که از دی اکسید کربن تغذیه میکند
محققان گونه ای آزمایشگاهی از باکتری اشریشیا کلی (Escherichia coli) توسعه داده اند که به جای شکرها و دیگر مولکول های ارگانیک، از دی اکسید ...
![]() ۹ آذر ۱۳۹۸
۹ آذر ۱۳۹۸
-
علمی دانشمندان برای اولین بار تغییر شکل باکتری در برابر آنتی بیوتیک را مشاهده کردند
باکتری ها به سرعت در حال تکامل بوده و در برابر داروها مقاوم می شوند. این موضوع سبب شده تا سازمان ملل متحد مقاومت باکتری ...
![]() ۹ مهر ۱۳۹۸
۹ مهر ۱۳۹۸
-
علمی این باکتری های فداکار برای حفاظت از همنوعان جان خود را فدا می کنند
باکتری ها بر خلاف سادگی ظاهری در ساختار، مکانیزم های جالبی برای دفاع از خود دارند؛ آنها در هنگام مواجهه با خطر یک غشای زیستی ...
![]() ۲۳ بهمن ۱۳۹۷
۲۳ بهمن ۱۳۹۷
-
علمی محققان راه جدیدی برای تولید برق با باکتری پیدا کردند
اصولاً کاربران با شنیدن کلمهی باکتری نگران میشوند و معمولاً آنها را چنان سودمند نمیداند اما باکتریهای مفید زیادی در طبیعت وجود دارند. برای مثال ...
![]() ۸ بهمن ۱۳۹۷
۸ بهمن ۱۳۹۷
-
علمی کشف ارتباط بهداشت نامناسب دهان و احتمال ابتلا به آلزایمر
آلزایمر از آن دسته بیماری هایی است که تا کنون منشا دقیقی برایش یافت نشده و اکثراً با ارائه راهکارهایی برای تقویت مغز، پیشگیری از ...
![]() ۷ بهمن ۱۳۹۷
۷ بهمن ۱۳۹۷
-
علمی توسعه حسگر زیستی ارزانی که عفونت را در لحظه تشخیص میدهد
در حالت عادی شناسایی باکتری های مضر در نمونه بیولوژیکی بیماران بین ۲ تا ۵ روز طول می کشد اما در این بازه ممکن است ...
![حسگر زیستی]() ۱۲ آذر ۱۳۹۷
۱۲ آذر ۱۳۹۷
-
تکنولوژی باکتریهای بیماری زا در ایستگاه فضایی بین المللی جاخوش کردهاند؟
محققان اخیراً نمونههایی از باکتری در ایستگاه فضایی بین المللی کشف کردهاند که در برابر برخی آنتی بیوتیکها از خود مقاومت نشان میدهند. این مسئله ...
![]() ۶ آذر ۱۳۹۷
۶ آذر ۱۳۹۷
-
علمی مصرف مداوم آنتی بیوتیک تولید باکتری های مفید روده را کاهش می دهد
تحقیقاتی جدید نشان میدهند که در صورت استفاده مکرر از آنتی بیوتیک ها، دیگر باکتریهای رودهی کمتری نسبت به قبل تولید خواهند شد. پژوهشگران دانشگاه ...
![]() ۵ آبان ۱۳۹۷
۵ آبان ۱۳۹۷
-
علمی تصویری از مونالیزا با استفاده از باکتری خلق شد
به تازگی دانشمندان ایتالیایی موفق شدهاند که با استفاده از باکتری اصلاح شدهی E. coli تصویری از مونالیزا را خلق کنند. پژوهشگران دانشگاه ساپینزا شهر رم سعی ...
![]() ۲۸ مرداد ۱۳۹۷
۲۸ مرداد ۱۳۹۷
-
علمی محققان از انتقال سریع باکتری ها بین مسافران مترو می گویند
در سال های اخیر مطالعات بسیاری در رابطه با باکتری های مترو صورت گرفته و همگی آنها در یک زمینه متفق القول بوده اند: مترو ...
![باکتری های مترو]() ۱۰ مرداد ۱۳۹۷
۱۰ مرداد ۱۳۹۷
-
علمی پژوهشگران از بارش ویروس و باکتری در تمام نقاط زمین می گویند
اگر عادت دارید با باز کردن پنجره ها هوای تازه تنفس کنید، شاید این خبر پشیمان تان کند. به تازگی دانشمندان دریافته اند در تمام ...
![]() ۱۹ بهمن ۱۳۹۶
۱۹ بهمن ۱۳۹۶
-
علمی محققان روشی را برای تبدیل مدفوع به غذا در سفرهای فضایی ابداع کرده اند
زندگی در سیاره ای دیگر ایده جالب و هیجان انگیزی به نظر می رسد با این حال برداشتن چالش های پیش رو مستلزم اقداماتی است ...
![باکتری]() ۸ بهمن ۱۳۹۶
۸ بهمن ۱۳۹۶

همچنین میتوانید جهت آگاهی از آخرین اخبار در حوزه تکنولوژی و اطلاع از بروزرسانی دیجیاتو مارا در شبکههای اجتماعی زیر نیز دنبال کنید. خوشحالیم که همراه ما هستید.